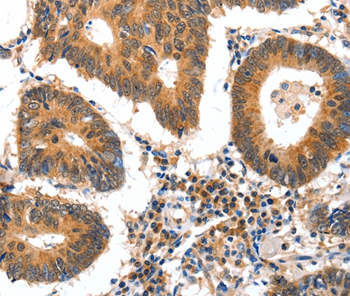

-
分类: 科研抗体货号: P42859别名: AAC11; AAC-11应用: WB反应种属: Human
-
分类: 科研抗体货号: P42833别名: APR; NOXA应用: IHC反应种属: Human
-
分类: 科研抗体货号: P42876别名: TCF-1应用: WB反应种属: Human,Mouse
-
分类: 科研抗体货号: P42856别名: GLUT5; GLUT-5应用: IHC反应种属: Human
-
分类: 科研抗体货号: P42831别名: Mi-er2; KIAA1193应用: WB,IHC反应种属: Human
-
分类: 科研抗体货号: P42874别名: YC1; MSSP; SCR2; HCC-4; MSSP-1; MSSP-2; MSSP-3; C2orf12应用: WB反应种属: Human
-
分类: 科研抗体货号: P42854别名: KFM; KFS; KFS1; KFSL; SGM1; BMP13; CDMP2; MCOP4; SCDO4; MCOPCB6应用: WB,IHC反应种属: Human
-
分类: 科研抗体货号: P42830别名: PAP1B; PAPIB; PAP IB; PAP-1B; UNQ429; LPPM429; REG III; REG-III应用: WB,IHC反应种属: Human,Mouse,Rat
-
分类: 科研抗体货号: P42871别名: NR1; MRD8; GluN1; NMDA1; NMDAR1应用: IHC反应种属: Human,Mouse,Rat
-
分类: 科研抗体货号: P42851别名: FHX应用: WB反应种属: Human,Mouse

鄂公网安备42018502007531号
鄂公网安备42018502007531号

